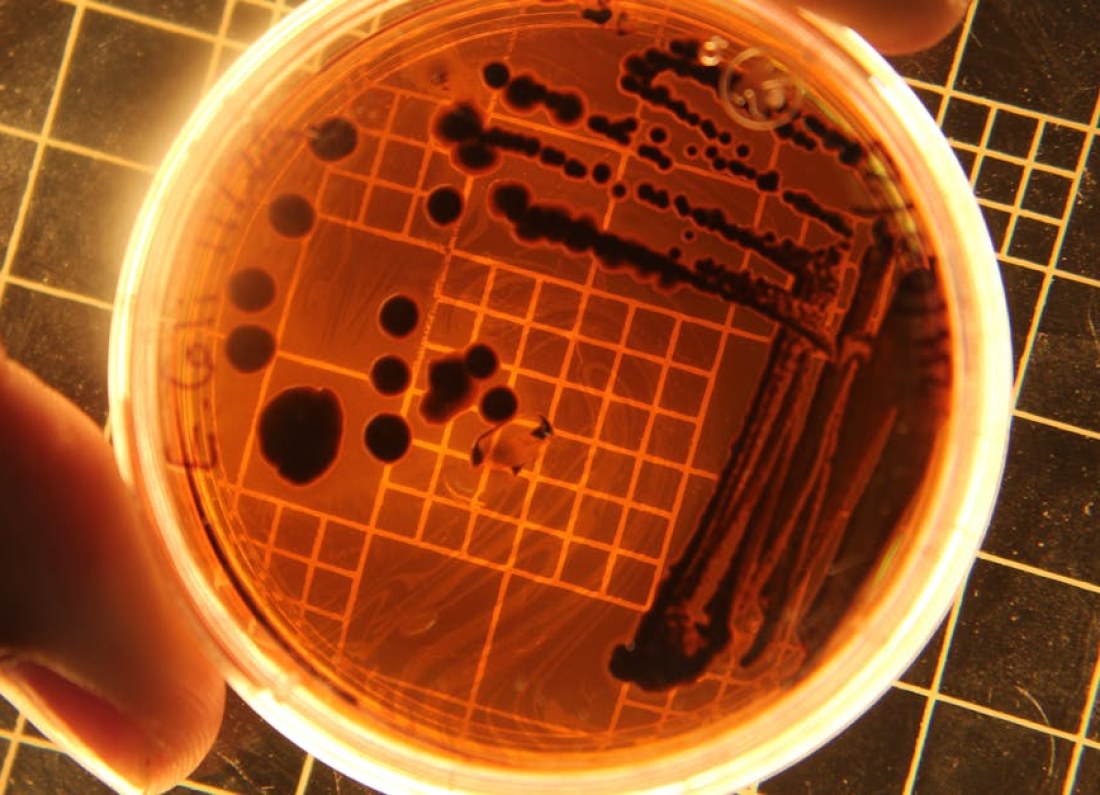
bacteria in space

Kulisy najdłuższej misji kosmicznej
Po niemal pół wieku nieprzerwanej pracy, legendarna sonda Voyager 1 ponownie zaskakuje naukowców. Zespół NASA podjął decyzję o wyłączeniu jednego z kluczowych podzespołów statku, aby oszczędzić resztki energii i utrzymać kontakt z Ziemią. To już kolejny etap walki o przedłużenie życia urządzenia, które od 1977 roku przemierza przestrzeń międzygwiezdną.
Według informacji opublikowanych przez serwis GRYOnline.pl, inżynierowie z Jet Propulsion Laboratory (JPL) postanowili odłączyć system odpowiedzialny za ogrzewanie niektórych instrumentów. Decyzja ta podyktowana jest malejącą mocą generowaną przez radioizotopowy generator termoelektryczny (RTG). Z każdym rokiem spada wydajność źródła zasilania, co zmusza zespół do priorytetyzowania najważniejszych funkcji sondy.
Jak działa ratowanie Voyagera?
Voyager 1 został zaprojektowany pierwotnie na pięcioletnią misję badawczą, której celem było zbadanie Jowisza i Saturna. Nikt w latach 70. nie przewidywał, że statek będzie działał tak długo. Dziś, gdy znajduje się już poza heliosferą, każdy wat energii ma znaczenie. NASA od lat stopniowo wyłącza kolejne podzespoły, w tym kamery i spektrometry, aby główne instrumenty naukowe mogły działać jak najdłużej.
Warto przypomnieć, że w 2023 roku doszło do poważnej usterki systemu komunikacji, która na kilka miesięcy przerwała odbiór danych. Inżynierom udało się jednak przywrócić łączność dzięki niestandardowym rozwiązaniom programistycznym. Obecne wyłączenie ogrzewania to kolejny krok w tej żmudnej konserwacji.
Znaczenie misji dla nauki
Dane przesyłane przez Voyagera 1 dostarczają bezcennych informacji o środowisku międzygwiezdnym. Sonda bada m.in. promieniowanie kosmiczne, pole magnetyczne oraz gęstość plazmy. Każdy dodatkowy miesiąc pracy oznacza nowe odkrycia, które mogą pomóc w zrozumieniu granic Układu Słonecznego.
Dr Emily Carter, astrofizyczka z Uniwersytetu Kalifornijskiego, podkreśla, że „Voyager 1 to nie tylko maszyna, ale symbol ludzkiej ciekawości i determinacji. Każde wyłączenie systemu to jednocześnie triumf inżynierii – udaje się utrzymać przy życiu urządzenie, które dawno powinno być martwe”.
Naukowcy szacują, że przy obecnym tempie zużycia energii, sonda może działać jeszcze przez kilka lat. Ostateczny kontakt z Ziemią planowany jest na około 2030 rok, gdy generator nie będzie już w stanie zasilać nawet podstawowych systemów łączności.
Foto: images.pexels.com

Leave a Reply